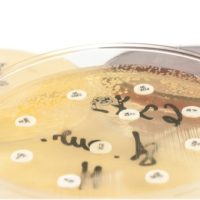
Antiobiotico resistenza: il cattivo uso del farmaco

L’Osservatorio Malattie Rare mette in guardia sui numeri in crescita della sindrome fibromialgica una patologia ancora non risconosciuta a livello ministeriale
Il termine fibromialgia deriva dal latino “fibra” a indicare i tessuti fibrosi come tendini e legamenti, e dal greco “mya”, muscolo, e “algos”, significa dunque dolore muscolare. Definita anche sindrome fibromialgica o sindrome di Atlante, è una patologia reumatica extra-articolare, riconosciuta nel 1992 dall’OMS. I sintomi più ricorrenti sono dolore cronico muscoloscheletrico, stanchezza, difficoltà di concentrazione, disturbi a carico di diversi apparati e più in generale un senso di affaticamento profondo e generalizzato. Nonostante non sia degenerativa o fatale, è un disturbo che può compromettere in modo importante la qualità di vita, in Italia ha un’incidenza fra il 2% e il 4% della popolazione e colpisce in maggioranza le donne.
Si tratta di fatto di una patologia invalidante per cui non esiste una cura, che attualmente non è riconosciuta a livello ministeriale, il che significa che i pazienti non hanno diritto all’esenzione e alle tutele previste per l’invalidità civile e l’handicap. Nonostante esistano linee guida e centri di riferimento per la gestione di questa sindrome, sono molte le esigenze di questi pazienti ancora insoddisfatte.
Tuttavia, il Ministro Speranza ha dichiarato che la Commissione nazionale per l’aggiornamento dei Lea e per l’appropriatezza del SSN sta esaminando e valutando la richiesta di inserimento della fibromialgia nei Livelli essenziali di assistenza, con le relative prestazioni specialistico ambulatoriale appropriate per il monitoraggio della malattia da concedere in regime di esenzione. L’Associazione Italiana Sindrome Fibromialgica (AISF-Odv) si batte per l’inserimento della patologia nei LEA e ha fornito all’Osservatorio Malattie Rare un approfondimento sui principali aspetti medici e sociali della fibromialgia.
Il dolore è il sintomo principale al quale guardare
Il dolore è il sintomo che maggiormente caratterizza la sindrome, che non è infiammatoria, ma è causata da un’alterazione della percezione del dolore stesso.
Come abbiamo già accennato, la sintomatologia più spesso riferita dai pazienti, ruota intorno a disturbi quali, un sonno disturbato, stanchezza, alterazioni neurocognitive e disturbi legati al sistema nervoso autonomo. Gli effetti della malattia sulla vita quotidiana dei pazienti sono molteplici e spesso possono portare a un allontanamento dal lavoro, difficile da mantenere per la compromissione fisica ma anche per le difficoltà di concentrazione, l’ansia e frequenti fenomeni depressivi; importanti anche le ripercussioni sulla vita sociale e di relazione.
L’approvazione della legge che riconosce la fibromialgia come malattia invalidante e inserisce la patologia nei LEA sarebbe un passo importante per i pazienti che ne soffrono, garantendo l’accesso alle prestazioni sanitarie e alle tutele previste per l’invalidità civile. L’inserimento nei LEA consentirebbe inoltre di prevedere un protocollo terapeutico univoco e standardizzato, garantendo ai pazienti una cura adeguata e una maggiore tutela.
Nella ricerca condotta dall’Istituto Piepoli in collaborazione con Aisf Odv e con il contributo di Alfasigma, sulla fibromialgia in Italia, emerge che la condizione di molti pazienti affetti da questa sindrome è amplificata dal sentirsi incompresi dagli altri. Interessanti i dati di attesa per la diagnosi, in media cinque anni, durante i quali una maggioranza importante di pazienti sperimenta terapie alternative come yoga e pilates. Circa il 63% dei pazienti, ha dichiarato di assumere integratori, solo il 14% si sente in buona salute, mentre la maggioranza ritiene di avere uno stato di salute precario.
Le conclusioni di questa indagine sottolineano la necessità di un approccio integrato e multispecialistico a questa patologia che consenta la dovuta assistenza al paziente e una sua educazione nell’approccio e gestione di questa sindrome.
Quali esami consigliamo in caso di sospetta sindrome fibromialgica
In caso di sospetta sindrome fibromialgica eseguiamo una serie di test in grado di fornire al terapeuta importanti indicazioni sullo stato di salute del paziente. Si tratta del pannello metabolomica + gut mini, un test combinato che consente un’analisi delle condizioni dell’intestino e delle tossine batteriche e fungine da esso derivate. Individua i valori nutrizionali associati a carenze vitaminiche o di antiossidanti, fornisce una risposta sull’efficienza dei sistemi detox e la funzionalità dei neurotrasmettitori insieme a diversi altri indicatori essenziali nel caso di sospetta sindrome fibromialgica.
Inoltre, per indagare le condizioni di questa tipologia di pazienti, è particolarmente utile il test sulle interleuchine salivari. Vengono indagate 8 interleuchine il cui ruolo è essenziale nell’attivazione e differenziazione delle cellule immunitarie, nonché nella proliferazione, maturazione, migrazione e adesione. Il test consente di rilevare il grado di attivazione di alcune di esse, alla base dei processi infiammatori.
Bibliografia:
- https://www.osservatoriomalattierare.it/fibromialgia
- https://www.osservatoriomalattierare.it/fibromialgia/18355-fibromialgia-un-indagine-rivela-i-bisogni-dei-pazienti-per-vivere-meglio